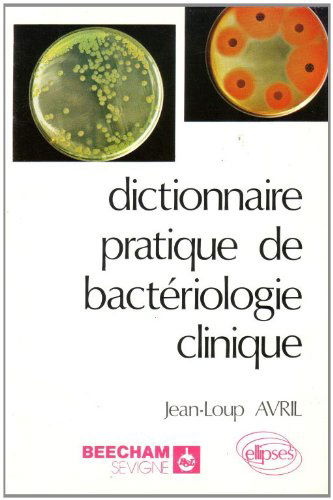
Bacteriologie clinique

Livres d’occasion sur la Vie professionnelle
Tout au long de la vie professionnelle d’une personne, il faut apprendre en permanence pour actualiser ses connaissances et rester compétent. Les connaissances qu’on acquiert pendant la période universitaire ne restent toujours pas pertinentes et les compétences demandées dans le monde professionnel évoluent constamment. Chez Recyclivre vous trouverez des livres professionnels d'occasion pour les secteurs de l’entreprise, de la bourse et du droit pour rester à la page, et ce à bas prix ! Lire la suite En voir moins
Affiner la sélection : Entreprise et Bourse, Droit